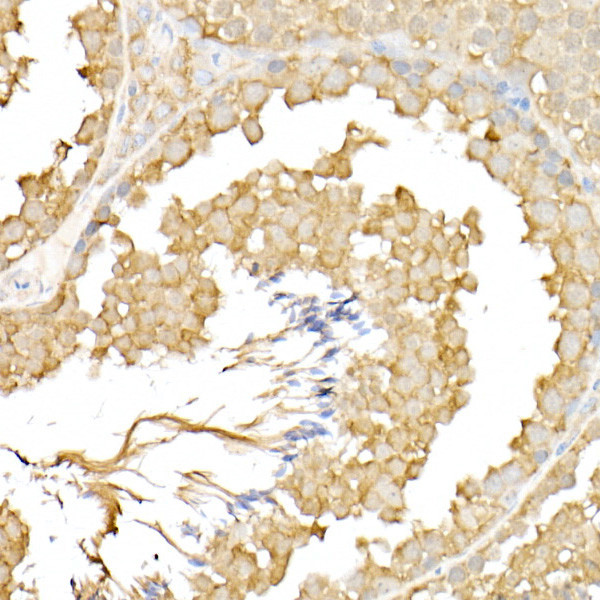
RPGR Antibody in Immunohistochemistry (Paraffin) (IHC (P))

Search
Invitrogen
RPGR Polyclonal Antibody
{{$productOrderCtrl.translations['antibody.pdp.commerceCard.promotion.promotions']}}
{{$productOrderCtrl.translations['antibody.pdp.commerceCard.promotion.viewpromo']}}
{{$productOrderCtrl.translations['antibody.pdp.commerceCard.promotion.promocode']}}: {{promo.promoCode}} {{promo.promoTitle}} {{promo.promoDescription}}. {{$productOrderCtrl.translations['antibody.pdp.commerceCard.promotion.learnmore']}}
图: 1 / 5
RPGR Antibody (PA5-95953) in IHC (P)





Please note: We are reviewing Western blot images included in the antibody testing data in our catalog, including those provided by third parties. Unless expressly labeled or annotated as “raw-unedited”, Western blot images included in the antibody testing data in our catalog may have been edited, optimized or otherwise adjusted for presentation.
产品信息
PA5-95953
种属反应
宿主/亚型
分类
类型
抗原
偶联物
形式
浓度
规格
纯化类型
保存液
内含物
保存条件
运输条件
RRID
产品详细信息
Immunogen sequence: MREPEELMPD SGAVFTFGKS KFAENNPGKF WFKNDVPVHL SCGDEHSAVV TGNNKLYMFG SNNWGQLGLG SKSAISKPTC VKALKPEKVK LAACGRNHTL VSTEGGNVYA TGGNNEGQLG LGDTEERNTF HVISFFTSEH KIKQLSAGSN TSAALTEDGR LFMWGDNSEG QIGLKNVSNV CVPQQVTIGK PVSWISCGYY HSAFVTTDGE LYVFGEPENG KLGLPNQLLG NHRTPQLVSE IPEKVIQVAC GGEHTVVLTE; Positive Samples: Y79, Mouse heart; Cellular Location: Cytoplasm, Golgi apparatus, centrosome, cilium axoneme, cilium basal body, cytoskeleton, flagellum axoneme, microtubule organizing center
靶标信息
This gene encodes a protein with a series of six RCC1-like domains (RLDs), characteristic of the highly conserved guanine nucleotide exchange factors. The encoded protein is found in the Golgi body and interacts with RPGRIP1. This protein localizes to the outer segment of rod photoreceptors and is essential for their viability. Mutations in this gene have been associated with X-linked retinitis pigmentosa (XLRP). Multiple alternatively spliced transcript variants that encode different isoforms of this gene have been reported, but the full-length natures of only some have been determined.
仅用于科研。不用于诊断过程。未经明确授权不得转售。
篇参考文献 (0)
生物信息学
蛋白别名: mRpgr; retinitis pigmentosa 15; retinitis pigmentosa 3 GTPase regulator; unnamed protein product; X-linked retinitis pigmentosa GTPase regulator; XLRP3
基因别名: COD1; CORDX1; CRD; orf15; PCDX; RP15; RP3; Rp3h; RPGR; XLRP3
UniProt ID: (Mouse) Q9R0X5
Entrez Gene ID: (Human) 6103, (Mouse) 19893, (Rat) 367733